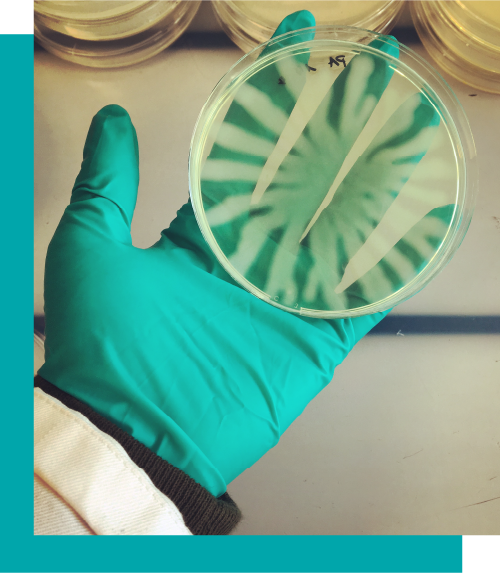
News

News

Der St. Galler Globus als verkleinertes 3D-Modell

Wohnrevue x Design ZHdK

BergAb mit ZHdK, WSL und SLF: die neue Info-App

Glacier Lifelines – The Future of Central Asia’s Water

Der LUNCHTALK geht in die nächste Runde unter dem Motto «Publizieren».

Infotag am 21. November 2025

Abschlussarbeiten an der Climate Week in New York

Bilder zwischen Vertrauen und Manipulation: Authentizität im digitalen Zeitalter

Zukunftsbilder Luzern

«Spinne sein» – unser Forschungsprojekt im Museum für Gestaltung Zürich

Zukunftsbilder zeigen klimaneutralen Kanton Luzern

REFRESH X Fantoche 2025

Designarbeiten aus Lehre und Forschung erleben

Graphic Novel «Dazwischen die Einsamkeit» von Simone Stolz

Buchvernissage – Dazwischen die Einsamkeit

Rückblick auf den Climate Content Day – Climate Storytelling …

Diplomausstellung Design 2025 und Einladung zur Vernissage Donnerstag, 5. Juni 2025

Einladung zur IceAgeCam – Ein Jahr interaktive Klimakommunikation

Der Lunch Talk geht in die nächste Runde

Symposium Climate Content Day

Jetzt bewerben!

Ausgezeichnete Diplomarbeiten

Showcase Design 2024

Infotag 2024

Wandbild «ROZHAN»

Sichtbar machen, was sich im Verborgenen abspielt

Relaunch des St.Galler Globus Online

Diplomprojekt «Proceed to Rescue» in Zusammenarbeit mit SOS …

Mit Virtual Reality ins Rheinfallbecken abtauchen

Auf Augenhöhe mit den Fischen im Rhein

ZHdK Förderpreis Design

Diplome 2024! – und ab in die Sommerpause

Zukunftsbilder Netto-Null

Diplomausstellung Design 2024 und Einladung zur Vernissage

Highlights aus dem Forschungsbericht 2023

Zukunftsbilder Netto Null

Lunchtalk mit dem Visual Design-Team des SRF

Expedition 2 Grad im Naturmuseum Winterthur – in der Sonderausstellung «Eiszeit»

Expedition 2 Grad an der Nachhaltigkeitswoche der Universität Basel 2024

Expedition 2 Grad im Ortsmuseum Meilen «Eisige Zeiten? – Von der Seegfrörni zur Gletscherschmelze»

Eröffnung der IceAgeCam auf der Felsenegg

Zeichnen und Illustrieren lernen - damals und heute

Eröffnung des Forschungsprojekts «IceAgeCam» auf der Felsenegg

Das neue Zett ist da!

Ab die Post!

Frohe Festtage

Kolloquium: Junior Research in Design

Erfolgreiche ZHdK-Forschende

Science Journalism meets Design

Wissenschaft langweilig und trocken?

Das ZHdK Spin-off «Somebodyelse» auf RTS

Das Game «Dissecting Love» gibt queeren Beziehungen mehr …

«Psychotic Bathtub» von Game Design Alumna am BLON Festival …

Game Design Alumna am A MAZE mit «Psychotic Bathtub» …

Projekte aus dem Departement Design bei «What’s next_Project» …

Game hilft bei der Rehabilitation von Kreuzbandrissen

Neuer Master Major Industrial Design

«100 Beste Plakate 22» im Toni-Areal

Bachelor Knowledge Visualization – Jetzt bewerben!

Junge Grafik 2023 kürt sechs ZHdK Grafik-Projekte

Geförderte Projekte im Junior Research in Design Programm 2023

Unterstütze die Kletterschuhe «hooq» via Crowdfunding

Infotag 2023

Zwei ZHdK Projekte gewinnen den «Design Preis Schweiz»

Ausstellung: Diplomprojekt «Grund genug» von Simone Stolz im Chäslager Stans

Die «Showcase Design 2023» Webseite ist online

Ein Festival zu drängenden Fragen unserer Zeit

Diplomprojekte für den «Prix Europa – Student Award» …

Hochparterre Campus über das Diplomprojekt «Bergdrama»

Wenn der Bergsturz droht

Die «Showcase Design 2023» Webseite ist online

New Realities: Design – Arts – Technology

Diplomprojekt «NEUNOI» im Fokus

Abgetaucht – Der versunkene Hafen von Horgen

Das Forschungsprojekt «Projekt CH+» unterstützt bei den …

Die Vogelnistplätze «Obru» im Hochparterre Magazin

Doppelerfolg für Diplomprojekte

Blick Magazin berichtet über das Diplomprojekt «The Real …

Mit der Gegenwart vernetzt

ZHdK Designprojekte nominiert für den «Design Preis Schweiz»

Knowledge Visualization an der Scientifica 2023

Expedition 2 Grad am Menuhin Musikfestival in Gstaad 2023

Mikro | Makro – eines der schönsten Bücher 2023!

Zu Gast an der Scientifica

Das Diplomprojekt «Shnosh – Identität Shipi» im Annabelle …

ZHdK Designer:innen an der diesjährigen Design Biennale Zürich

Das Diplomprojekt «Chaos Cuisine» im Hochparterre Magazin

Die Website «Jeansdinge» ist online

Diplome 2023! – und ab in die Sommerpause

Feierliche Preisverleihungen im Rahmen der Diplomfeier Design

Gender Design Award «iphiGenia» 2023

Eine App, die Gefühle zeigt

Gender Design Award «iphiGenia» 2023 für zwei ZHdK-Projekte

Das Game «Psychotic Bathtub» im Hochparterre Magazin

ExerUp! Forschungsbasierte Entwicklung eines Exergames für die …

Interaction Design Masterarbeit ist Teil der neuen Ausstellung im …

Nomination für den Gender Design Award «iphiGenia» 2023

Diplome Knowledge Visualization 2023

Neue Energie für alte Gebäude

Science Lunch #6 mit Heini Wernli & Nicolas Gruber

ZHdK Alumni nominiert für die Swiss Design Awards

Eine Tiktok-Serie über soziale Phobie

«Verlust – die andere Seite des Fortschritts» Vortrag von …

ZHdK Forschungsbericht 2022

Call for Projects: Innovatives Publizieren in Open Science

Inklusives Design: Projekt Circleg an der Milano Design Week …

Von anderen lernen, für andere entwickeln

Sterben gestalten – Ausstellung und Tagung

Design für den OP

Langlebige Kopfhörer

Ausstellung Gewerbemuseum "The Bigger Picture"

DIZH-Innovationsprogramm fördert neun Projekte aus dem Design

Wie die Künste forschen: «Tag der Forschung» an der ZHdK

Ausstellung «Game Design Today»
Veranstaltung: «Tag der Forschung 2023»

Ausstellung «Game Design Today»

Förderung für zwei innovative Publikationsprojekte

Pac-Man gibt’s hier nicht zu sehen

Erste Schweizer TikTok Serie über Social Anxiety

Eine Überdosis Globuli

Kolloquium: Junior Research in Design

Frohe Festtage

Interview zu «oHealth» auf Hochparterre Campus

Knowledge Visualization meets Veterinary Pathology

Sleeve für trans Männer mit Neophallus

Der Virtuelle Gletscher trifft auf 200 Jahre altes Alpen-Relief

ZHdK Startup Finder

Lancierung «Design Market», eine Initiative des Departements …

100 Beste Plakate 21

«Expedition 2 Grad» an der Science Week Berlin 2022

Ein Pop-up Event zum Bodensee Stonehenge

Digital und Online: Der St. Galler Globus

Publikation: «Give Us a Break! Arbeitermilieu und Designszene im …

Linking Cultures: Students for Students Presentations 2022

Infotag 2022

Zürich meets Berlin

«Animation – Exponate zum Leben erwecken» Kooperation mit dem Landesmuseum Zürich

Von Engelberg bis nach Berlin – unsere VR-Glaciers auf Tournee

Das Departement Design an der «Berlin Science Week»

Virales TikTok Projekt mit Eyes & Ears Award honoriert

Lancierung Showcase Design 2022

Game-Entwicklerin Philomena Schwab im Porträt bei Blick.ch

Research Day «Ageing Futures – Design. Gesellschaft. …

«Heilpflanzen am Wegesrand entdecken» mit Illustrationen von Jasmin Huber

Lancierung Showcase Design 2022

AQUA:TOFANA im SRF Kulturplatz

Konferenz: "Counterparts – Exploring Design Beyond the Human"

Cinebulletin berichtet über «REFRESH X Fantoche»

Ausstellung «REFRESH X Fantoche»

Infoveranstaltung Master Design 2022

Master Applications 2022 Open Now!

Beiträge aus dem Departement Design an den Zurich Design Weeks

Neue Junior Research in Design Projekte

Rückblick Diplomausstellung 2022

«Track-track: Let’s follow the cat!» received Best Demo …

Förderung für das «Digital Health Design Living Lab»

ZHdK erhält mehrjährige DIZH-Förderung zu Digital Health …

Diplomabschluss 2022: Herzliche Gratulation!

Ein «Gesicht» für das Kinderhospiz Flamingo

Preisträger:innen Förderpreis Design und SDA-Award 2022

ADC Student of the year: Auszeichnungen für Projekte von …

Design-Alumni beim Schweizer Designpreis ausgezeichnet

Diplomausstellung Design 2022

Neue SNF-Projektförderung der Fachrichtungen Game Design und …

Neue SNF-Projektförderung der Fachrichtungen Game Design und …

Diplome Knowledge Visualization 2022

Identität rekonstruieren

Science Lunch #7 mit Noah Bubenhofer und Masterstudierenden

Spinne sein – ein arachnozentrisches Erlebnis

Science Lunch #6 mit Kenza Benabderrazik & Natascha Jankovski

Neue Forschungskooperation zu Blockgletschern im Schweizerischen Nationalpark

Science Lunch #5 mit Martin Fischer, Jonas Lauströer & Amir Andikfar

Science Lunch #4 mit Florianne Koechlin

Science Lunch #3 mit Alexander Kocyan

VR Glacier Experiences an der ETH

«Swiss it on Wheels» – Eine Design Kollaboration für Schweizer Umweltworkshops in Indien
Science Lunch #2 mit Alex Hall und Fabienne Benz

Science Lunch #1 mit Denis Cliofas und Johannes Kiesbauer

Science Lunch 2022 live!

«Das immersive Arbeitsheft» im SRF Digital Podcast

Briefmarkenserie «Weihnachtsbräuche» von bunterhund Illustration

BA-Knowledge Visualization 2022 – Jetzt bewerben!

VR Glacier Experience an der Eröffnungsfeier des Dossiers Nachhaltigkeit ZHdK

Knowledge Visualization im Grafikmagazin

Am 26. November ist Infotag

Veranstaltungshinweis

So sah Zürich vor 20'000 Jahren aus

«Expedition 2 Grad» und «VR Glacier Experience» an der COP26

VR Glacier Experience auf Arte – Dienstag 28.9., 19:40

Infotag MA Design am 1. Oktober

Expedition 2 Grad und VR Glacier Experience an der Scientifica

Master Applications Open Now!

Expedition 2 Grad im Museum für Kommunikation in Bern

MA-Absolventin Livia Enderli gewinnt den Förderpreis Design 2021 im Master-Studiengang

Online Diplomausstellung 2021

Veranstaltungen Diplom Knowledge Visualization 2021

Science & Design Round Table Di. 22. Juni

Die «Expedition 2 Grad» ist zu Gast an der Cumulus Konferenz Rom 2021

Die Glacier Experiences an der Architekturbiennale Venedig 2021

Science Lunch #7 mit Sarah Kenderdine

Science Lunch #6 mit Mirja Nolff & Jeanne Peter

Science Lunch #5 mit Mike Schäfer

Science Lunch #4 mit Martina Polig

Science Lunch #3 mit Tim Haye

Science Lunch #2 mit Angelika Jacobs, Sebastian Gibis und Annette Roulier

Meet the Masters 1. März

Science Lunch #1 mit Joanna Sleigh

Science Lunch 2021 online!

Briefmarken zu 125 Jahren Kinokultur

Ulrike Meyer Stump publiziert erste Karl Blossfeldt-Monografie

NZZaS-Infografik-Team unter Alumna Elisa Forster wird mit «European Newspaper Award» ausgezeichnet

«Unscheinbar, grossartig, selten» als Postkarten und Poster erhältlich

Am 27. November ist Infotag

Online-Diplomausstellung 2020

VR Glacier Experience Eröffnung in Diavolezza

Unser Forschungsprojekt Expedition 2 Grad ist für den Bundespreis Ecodesign 2020 nominiert!

Schon von unserem Masterstudium gehört?

Infoveranstaltung Master Design am 2. Oktober

Master Applications Open!

Diplomabschluss 2020: Herzliche Gratulation!

Interview mit der Diplomandin Nina Schwarz

Science Design Festival

Veranstaltungen Diplom Knowledge Visualization 2020

Science Lunch #8 als Online Konferenz mit Tobias Frey

Science Lunch #7 als Online Konferenz mit Uwe Brückner

Science Lunch #6 Online Konferernz mit Adrian Meyer

«Einstein»-Sendung mit Visualisierungen von Ikonaut

Science Lunch #5 als Online Konferenz mit Katja Liebal

Science Lunch #4 als Online Konferenz mit Philippe Cattin

Science Lunch #3 als Online Konferenz mit Christian Erni

Science Lunch 2020 goes Online!

Schwarz auf Weiss. Politische Zeichnungen und Bildräume.

Science Lunch #2 mit Wilhelm Bloch, Anncharlott Berglar und Oliver Bruderer
Aufnahmeprüfung BA-Studium 2020: wichtigste Termine

Science-Apéro im Museum für Gestaltung

KVIS-Diplomprojekte auf Tournee

Dank Fröschen zum Traumberuf

Wissen in Bildern – Informationsdesign heute

Mit virtuellem Klima-Fiebermesser an der Scientifica

Ein virtueller Rundgang durch unsere Diplomausstellung 2019

Tangible Virtual Models bei Digitalswitzerland

Diplomabschluss 2019: Herzliche Gratulation!

Diplom-Ausstellung

Eine prähistorische Liebesgeschichte

Infoveranstaltung Master Design

Letzter Science Lunch in diesem Semester mit Nicolas Antille am 20. Mai 2019

Science Lunch mit Christian Huggel und Veruska Muccione am 8. Mai 2019

Designstudentin Chi Lui Wong im Porträt auf Zett Online

Science Lunch mit Phillipp Ackermann am 24. April 2019

Unsere Titanwurz an der Ausstellung «Von Pflanzen und Menschen» in Dresden

Expedition 2 Grad in der Tagesschau

Science Lunch mit Johannes Rebsamen & Matthias Vollmer am 10. April 2019

Expedition 2 Grad – Vernissage am 2. April 2019

Science Lunch mit Jürg Meyer & Thomas Buckingham am 27. März 2019

Bunter Einstieg in die Therapie – Alumna Coralie Spätigs Bachelorarbeit ist nun käuflich erhältlich

Expedition 2 Grad – Wie Virtual Reality zu einer Verhaltensänderung beiträgt

Science Lunch mit Eberhard Zangger am 06. März 2019

Neue Edition des Science Lunch ab 6. März 2019

AKTLABOR FS 2019

Orobates in der Zeitschrift «Nature»

Kleine Weltwunder im Jurapark Aargau

Expedition 2 Grad bei «Spaceification»

Armin Coray erhält die Ehrendoktorwürde der Universität Basel

Die goldene Feder des Coucou geht an Balthasar Bosshard

Kirschen nach Übersee

Illustrators' Lunch mit Simeon Schaffner am 05. Dezember 2018

Anne Seeger und Andrea Klaiber belegen 2. Platz beim Infografik-Award der Deutschen Presseagentur

Ein virtueller Rundgang durch unsere Diplomausstellung 2018

Illustrators' Lunch mit Michel Casarramona am 21. November 2018

Infotag Design am 23. November 2018

Symposium: Visual E-Didactics am 16. November

Illustrators' Lunch mit Stephan Schmitz am 07. November 2018

Beobachter gewinnt Infografikpreis

Illustrators' Lunch mit Marina Bräm am 24. Oktober 2018

Das war der AEIMS-Kongress 2018

Master Knowledge Visualization: Applications open until October 29th

«Erlebnis Nahrung» an der Olma

AKTLABOR

KÖRPER ZEICHNEN

Illustrators' Lunch mit Jared Muralt am 10. Oktober 2018

Unsere Titanwurz am Hongkong Design Institute

SEEING SCIENCE Exhibition

27. AEIMS Kongress 2018

Master Erkenntnis-Visualisierung: Anmeldung öffnet am 27. August!

Infoveranstaltung Master Design am 4. Oktober

Bachelorabschluss 2018: Herzliche Gratulation!

Stellenausschreibung: 3D-Visualisierung Entwicklung/Evolution von Tieren

Diplomausstellung 2018

Tangible Virtual Models am 3daysofdesign in Kopenhagen

Science Lunch mit Wolfgang Neubauer

Science Lunch mit Tobias Krapf am 2. Mai

Was tut sich so im Master?

Science Lunch mit Georg Feitscher und Dr. Tobias Schlechtriemen am 18. April

Sommeratelier: Workshops für Teens!

Science Lunch mit Anne Schulp am 4. April

Hot Hot Hot

Neue Edition des Science Lunch ab 28. März

Die Gerichtszeichnerin

Erster internationaler Modellathon in Köln

MAD Chit Chat am 21. Februar

Jetzt erhältlich: Haie – Die perfekten Jäger

Der Insektenzeichner

Illustrators’ Lunch mit Diego Balli am 10. Januar

Neuer Termin: Illlustrators’ Lunch mit Konrad Beck am 17. Januar

«Hic et Nunc» gewinnt den Goldenen Hasen

Jetzt im Buchhandel: Jasmin Hubers Kirschenillustrationen

Knowledge Visualization zu Besuch in Berlin

Illustrators’ Lunch mit Felice Bruno am 13. Dezember

Illustrators’ Lunch mit Lucille Solomon am 29. November

«Nach dem ewigen Eis»: Ausstrahlung auf SRF 1 am 29. November

Vom Wissensbild zum virtuellen Modell – Talk im Kunstgewerbemuseum Berlin am 14. Dezember

Titanwurz: Auftritt am HB Zürich am 21. November
Zwei neue Dozierende in unserer Fachrichtung

Tag der Forschung am 17. November

Junior Design Research Conference am 10. November

Masterstudium: Anmeldefrist bis 30. 11. 2017 verlängert

Illustrators’ Lunch mit Corinne Schroff am 1. November

Infotag Design 2017 am 24. November 2017

Illustrators’ Lunch mit Janine Wiget am 18. Oktober 2017

Expanding Immersive Design am 21. November 2017

We ♥︎ Langwies

Illustrators’ Lunch – Curated by Students

Ein neues Semester beginnt

Infoveranstaltung Master of Arts in Design 2017

«Closing the Cleft» in Dresden

Symposium «Epistemische Bilder» am 29. September 2017

Eloisa Aldomar gewinnt den Förderpreis der Hochschulleitung

Ready for take-off? — Ready!

Swiss Design Awards 2017 – Auszeichnung für Thomas Ott

Diplomausstellung 2017

Willkommen auf unserer neuen Website
